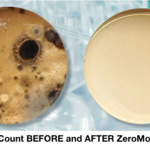

Serving Franklin, TN and surrounding areas
Approved
In business since 2010
Free estimates
Warranties offered
"Our technician Patrick was courteous and friendly. He explained everything he was doing to remove the mold we had in our bathroom and how to prevent it from happening again. He never pressured us for additional services and seemed extremely genuine in his approach to helping us. I highly recommend this company."

+3
























































